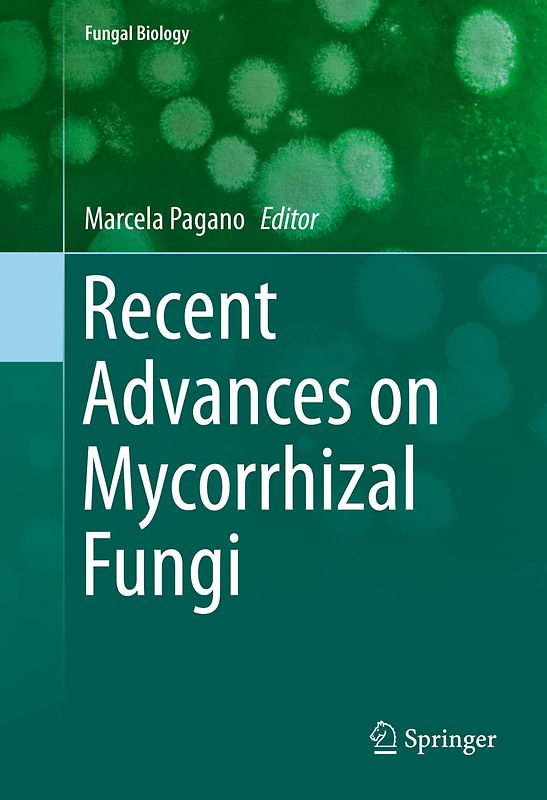
Recent Advances on Mycorrhizal Fungi

Handgeprüfte Gebrauchtware
Bis zu 50 % günstiger als neu
Der Umwelt zuliebe
Handgeprüfte Gebrauchtware
Bis zu 50 % günstiger als neu
Der Umwelt zuliebe
Hersteller: Springer Nature Customer Service Center GmbH, Europaplatz 3, Heidelberg, Deutschland, 69115, ProductSafety@springernature.com
